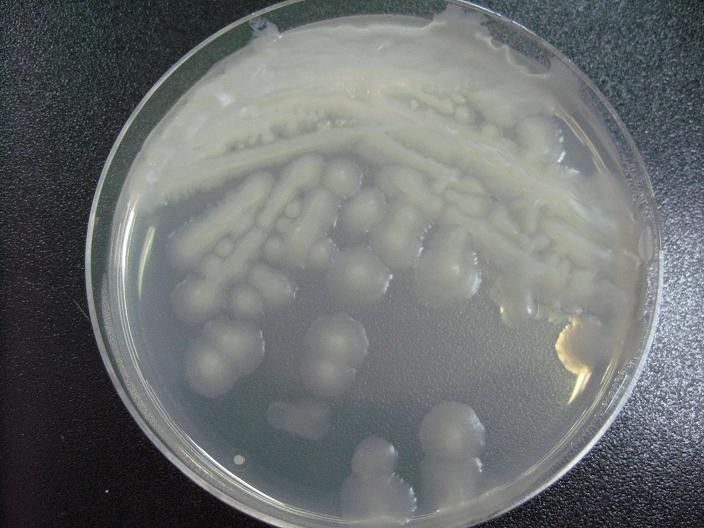
雷斯青霉图片

万千商家帮你免费找货
0 人在求购买到急需产品
- 详细信息
- 技术资料
- 库存:
35
- 英文名:
Penicillium│raistrickii G. Sm.
- 保质期:
详见说明书
- 供应商:
上海邦景
- 保存条件:
低温冷藏
- 规格:
详见说明书
公司专业代理ATCC菌种,雷斯青霉图片价格优惠,质量保证,为大中型科研提供严格质量体系控制的ATCC,CMCC,CICC,DSMZ标准菌株。
中文名称 雷斯青霉图片
种属 Penicillium│raistrickii G. Sm.
分离基物 马尾松
提供形式 斜面培养物
安全等级 1
模式菌株 no
培养方法
培养基 14
生长条件 25
存储条件 定期移植法

保藏方法:
1. 传代培养保藏法
又有斜面培养、穿刺培养、疱肉培养基培养等(后者作保藏厌氧细菌用),培养后于4-6℃冰箱内保存。
2. 液体石蜡覆盖保藏法
是传代培养的变相方法,能够适当延长保藏时间,它是在斜面培养物和穿刺培养物上面覆盖灭菌的液体石蜡,一方面可防止因培养基水分蒸发而引起菌种死亡,另一方面可阻止氧气进入,以减弱代谢作用。
3. 载体保藏法
是将微生物吸附在适当的载体,如土壤、沙子、硅胶、滤纸上,而后进行干燥的保藏法,例如沙土保藏法和滤纸保藏法应用相当广泛。
4. 寄主保藏法
用于目前尚不能在人工培养基上生长的微生物,如病毒、立克次氏体、螺旋体等,它们必须在生活的动物、昆虫、鸡胚内感染并传代,此法相当于一般微生物的传代培养保藏法。病毒等微生物亦可用其他方法如液氮保藏法与冷冻干燥保藏法进行保藏。
5. 冷冻保藏法可分低温冰箱(-20-30℃,-50-80℃)、干冰酒精快速冻结(约-70℃)和液氮(-196℃)等保藏法。
操作流程:
菌株复苏:(按三区划线法将留菌管内的原始菌株进行复苏)
1) 所有菌株,显色培养基分4区,每区一株,标明菌株号、菌种名常用缩写如下:
cal: 白念珠菌 cgl:光滑念珠菌 cpa: 近平滑念珠菌 ctr: 热带念珠菌 ckr: 克柔念珠菌 cne: 新型隐球菌,其他菌种标记全名。
2) 隐球菌除传显色培养基以外,另传1/2块血平皿上述菌株统一37oC孵育48h
菌种鉴定:(48h后观察结果)。
雌酚酮 HPLC≥98% 20mg BJ5183细菌1毫升
大风子素 HPLC≥98% 10mg BLOTTO10核酸杂交封闭溶液100毫升
黄嘌呤 HPLC≥98% 20mg BLOTTO-10核酸杂交封闭溶液100毫升
野鸢尾黄素 HPLC≥98% 20mg BMGY培养基100/500毫升
刺甘草查尔酮 HPLC≥98% 20mg BMMY培养基100/500毫升
刺芒柄花苷 HPLC≥98% 20mg BorreliaburgdorferiRFLP基因分析试剂盒20
刺囊酸 HPLC≥98% 20mg Bosc23包装细胞克隆选择培养基500毫升
刺桐碱 HPLC≥98% 20mg Bouin固着液50毫升
刺五加苷E HPLC≥98% 20mg BovineacetoneELISA试剂盒牛同检测(acetone)ELISA试剂盒规格:96T/48T
刺五加皂苷B HPLC≥98% 20mg BPE蛋白标记试剂盒(不含BPE)3(1毫克/)
L-(-)-葡萄糖(标准品) L-(-)-Glucose 质量规格:>98%,标准品 ELISAKitFibrin人血纤蛋白规格:48T/96T
7-酮基去氢表雄酮 7-Keto-dehydroepiandrosterone 质量规格:>98% 小鼠肌肝(Cr)ELISA试剂盒 组装/原装
硝酸铷 Rubidium nitrate 质量规格:>99% Rat lymphocyte function associated aigen 3 (LFA-3/CD58) ELISA Kit 大鼠细胞功能相关抗原3(LFA-3/CD58)ELISA试剂盒
CHIR-99021 (CT99021.HCl) CHIR-99021 (CT99021) HCl 质量规格:>99%,GSK-3α/β抑制剂 Humaetinolbindingprotein,RBPELISAKit 人视黄醇结合蛋白(RBP)ELISA试剂盒 96T/48T 进口分装
骆驼蓬碱;骆驼蓬灵;哈梅灵(标准品) Harmaline;Dihydroharmine 质量规格:HPLC≥98%,标准品 Humanai-lymphocytotoxicaibody,ALA/LCAELISA试剂盒人抗细胞毒抗体(ALA/LCA)ELISA试剂盒规格:96T/48T
阿卡地新(AICAR) Acadesine 质量规格:>98%,BR 植物尿苷二0酸葡萄糖焦0酸化酶(UDPglucosepyrophosphorylase)活性比色法定量检测试剂盒20
蒲公英萜醇;蒲公英赛醇(标准品) Taraxerol 质量规格:HPLC≥98%,标准品 Humanurokinase-typeplasminogenactivator,uPA/PLAUELISAKit人激肽释放酶8(KLK8)ELISA试剂盒规格:96T/48T
琥珀酸普卡必利 Prucalopride Succinate 质量规格:>98%,BR 小鼠肌钙蛋白T(Tn-T)ELISA试剂盒 ,英文名: Tn-T ELISA Kit
盐酸纳洛酮 Naloxone HCl dihydrate 质量规格:>98%,二水合物, 大鼠白介素23(IL-23)ELISA检测试剂盒RatIerleukin23,IL-23ELISAKit 96T/48T
硝酸布康唑 Butoconazole nitrate 质量规格:>98%,BR 人补体片断5a(C5a)试剂盒 Human Compleme fragme 5a,C5a ELISA Kit
BJ5183细菌1毫升 雌酚酮 HPLC≥98% 20mg
BLOTTO10核酸杂交封闭溶液100毫升 大风子素 HPLC≥98% 10mg
BLOTTO-10核酸杂交封闭溶液100毫升 黄嘌呤 HPLC≥98% 20mg
BMGY培养基100/500毫升 野鸢尾黄素 HPLC≥98% 20mg
BMMY培养基100/500毫升 刺甘草查尔酮 HPLC≥98% 20mg
BorreliaburgdorferiRFLP基因分析试剂盒20 刺芒柄花苷 HPLC≥98% 20mg
Bosc23包装细胞克隆选择培养基500毫升 刺囊酸 HPLC≥98% 20mg
Bouin固着液50毫升 刺桐碱 HPLC≥98% 20mg
BovineacetoneELISA试剂盒牛同检测(acetone)ELISA试剂盒规格:96T/48T 刺五加苷E HPLC≥98% 20mg
BPE蛋白标记试剂盒(不含BPE)3(1毫克/) 刺五加皂苷B HPLC≥98% 20mg
雷斯青霉图片大鼠戊糖素(Peosidine)试剂盒 Rat advanced glycation end products,AGEs ELISA Kit 甲基泼尼松 Meprednisone 质量规格:>98%,BR
英文名称RatFBELISAKit大鼠纤维蛋白原(FB)规格:96T/48T 甲基泼尼松(标准品) Meprednisone 质量规格:>98%,标准品
核固红复染试剂盒50 阿普斯特;CC10004 Apremilast;CC-10004 质量规格:>98%,PDE4和TNF-α抑制剂
ELISAKitFibrin人血纤蛋白规格:48T/96T L-(-)-葡萄糖(标准品) L-(-)-Glucose 质量规格:>98%,标准品
小鼠肌肝(Cr)ELISA试剂盒 组装/原装 7-酮基去氢表雄酮 7-Keto-dehydroepiandrosterone 质量规格:>98%
Rat lymphocyte function associated aigen 3 (LFA-3/CD58) ELISA Kit 大鼠细胞功能相关抗原3(LFA-3/CD58)ELISA试剂盒 硝酸铷 Rubidium nitrate 质量规格:>99%
Humaetinolbindingprotein,RBPELISAKit 人视黄醇结合蛋白(RBP)ELISA试剂盒 96T/48T 进口分装 CHIR-99021 (CT99021.HCl) CHIR-99021 (CT99021) HCl 质量规格:>99%,GSK-3α/β抑制剂
Humanai-lymphocytotoxicaibody,ALA/LCAELISA试剂盒人抗细胞毒抗体(ALA/LCA)ELISA试剂盒规格:96T/48T 骆驼蓬碱;骆驼蓬灵;哈梅灵(标准品) Harmaline;Dihydroharmine 质量规格:HPLC≥98%,标准品
植物尿苷二0酸葡萄糖焦0酸化酶(UDPglucosepyrophosphorylase)活性比色法定量检测试剂盒20 阿卡地新(AICAR) Acadesine 质量规格:>98%,BR
Humanurokinase-typeplasminogenactivator,uPA/PLAUELISAKit人激肽释放酶8(KLK8)ELISA试剂盒规格:96T/48T 蒲公英萜醇;蒲公英赛醇(标准品) Taraxerol 质量规格:HPLC≥98%,标准品
概念:
一,菌种的概念 原意是指孢子(相当于植物的种子) ,但在实际生产中,常将经过人工培养的纯菌丝体连同培养基质一同叫做菌种。
二,菌种的类型 在生产中根据菌种的来源,繁殖代数及生产目的,把菌种分为母种,原种和栽培种.分别叫一级种,二级种,三级种。
母种:将纯菌丝体或孢子在试管培养基中繁殖而成.可以繁殖原种,也适宜菌种保藏.
原种:母种菌丝在固体培养基上繁殖而成.这一过程增强菌丝对培养环境的适应性,又起到扩繁的作用.原种可以直接出菇。
中文名称 雷斯青霉图片
种属 Penicillium│raistrickii G. Sm.
分离基物 马尾松
提供形式 斜面培养物
安全等级 1
模式菌株 no
培养方法
培养基 14
生长条件 25
存储条件 定期移植法

保藏方法:
1. 传代培养保藏法
又有斜面培养、穿刺培养、疱肉培养基培养等(后者作保藏厌氧细菌用),培养后于4-6℃冰箱内保存。
2. 液体石蜡覆盖保藏法
是传代培养的变相方法,能够适当延长保藏时间,它是在斜面培养物和穿刺培养物上面覆盖灭菌的液体石蜡,一方面可防止因培养基水分蒸发而引起菌种死亡,另一方面可阻止氧气进入,以减弱代谢作用。
3. 载体保藏法
是将微生物吸附在适当的载体,如土壤、沙子、硅胶、滤纸上,而后进行干燥的保藏法,例如沙土保藏法和滤纸保藏法应用相当广泛。
4. 寄主保藏法
用于目前尚不能在人工培养基上生长的微生物,如病毒、立克次氏体、螺旋体等,它们必须在生活的动物、昆虫、鸡胚内感染并传代,此法相当于一般微生物的传代培养保藏法。病毒等微生物亦可用其他方法如液氮保藏法与冷冻干燥保藏法进行保藏。
5. 冷冻保藏法可分低温冰箱(-20-30℃,-50-80℃)、干冰酒精快速冻结(约-70℃)和液氮(-196℃)等保藏法。
操作流程:
菌株复苏:(按三区划线法将留菌管内的原始菌株进行复苏)
1) 所有菌株,显色培养基分4区,每区一株,标明菌株号、菌种名常用缩写如下:
cal: 白念珠菌 cgl:光滑念珠菌 cpa: 近平滑念珠菌 ctr: 热带念珠菌 ckr: 克柔念珠菌 cne: 新型隐球菌,其他菌种标记全名。
2) 隐球菌除传显色培养基以外,另传1/2块血平皿上述菌株统一37oC孵育48h
菌种鉴定:(48h后观察结果)。
雌酚酮 HPLC≥98% 20mg BJ5183细菌1毫升
大风子素 HPLC≥98% 10mg BLOTTO10核酸杂交封闭溶液100毫升
黄嘌呤 HPLC≥98% 20mg BLOTTO-10核酸杂交封闭溶液100毫升
野鸢尾黄素 HPLC≥98% 20mg BMGY培养基100/500毫升
刺甘草查尔酮 HPLC≥98% 20mg BMMY培养基100/500毫升
刺芒柄花苷 HPLC≥98% 20mg BorreliaburgdorferiRFLP基因分析试剂盒20
刺囊酸 HPLC≥98% 20mg Bosc23包装细胞克隆选择培养基500毫升
刺桐碱 HPLC≥98% 20mg Bouin固着液50毫升
刺五加苷E HPLC≥98% 20mg BovineacetoneELISA试剂盒牛同检测(acetone)ELISA试剂盒规格:96T/48T
刺五加皂苷B HPLC≥98% 20mg BPE蛋白标记试剂盒(不含BPE)3(1毫克/)
L-(-)-葡萄糖(标准品) L-(-)-Glucose 质量规格:>98%,标准品 ELISAKitFibrin人血纤蛋白规格:48T/96T
7-酮基去氢表雄酮 7-Keto-dehydroepiandrosterone 质量规格:>98% 小鼠肌肝(Cr)ELISA试剂盒 组装/原装
硝酸铷 Rubidium nitrate 质量规格:>99% Rat lymphocyte function associated aigen 3 (LFA-3/CD58) ELISA Kit 大鼠细胞功能相关抗原3(LFA-3/CD58)ELISA试剂盒
CHIR-99021 (CT99021.HCl) CHIR-99021 (CT99021) HCl 质量规格:>99%,GSK-3α/β抑制剂 Humaetinolbindingprotein,RBPELISAKit 人视黄醇结合蛋白(RBP)ELISA试剂盒 96T/48T 进口分装
骆驼蓬碱;骆驼蓬灵;哈梅灵(标准品) Harmaline;Dihydroharmine 质量规格:HPLC≥98%,标准品 Humanai-lymphocytotoxicaibody,ALA/LCAELISA试剂盒人抗细胞毒抗体(ALA/LCA)ELISA试剂盒规格:96T/48T
阿卡地新(AICAR) Acadesine 质量规格:>98%,BR 植物尿苷二0酸葡萄糖焦0酸化酶(UDPglucosepyrophosphorylase)活性比色法定量检测试剂盒20
蒲公英萜醇;蒲公英赛醇(标准品) Taraxerol 质量规格:HPLC≥98%,标准品 Humanurokinase-typeplasminogenactivator,uPA/PLAUELISAKit人激肽释放酶8(KLK8)ELISA试剂盒规格:96T/48T
琥珀酸普卡必利 Prucalopride Succinate 质量规格:>98%,BR 小鼠肌钙蛋白T(Tn-T)ELISA试剂盒 ,英文名: Tn-T ELISA Kit
盐酸纳洛酮 Naloxone HCl dihydrate 质量规格:>98%,二水合物, 大鼠白介素23(IL-23)ELISA检测试剂盒RatIerleukin23,IL-23ELISAKit 96T/48T
硝酸布康唑 Butoconazole nitrate 质量规格:>98%,BR 人补体片断5a(C5a)试剂盒 Human Compleme fragme 5a,C5a ELISA Kit
BJ5183细菌1毫升 雌酚酮 HPLC≥98% 20mg
BLOTTO10核酸杂交封闭溶液100毫升 大风子素 HPLC≥98% 10mg
BLOTTO-10核酸杂交封闭溶液100毫升 黄嘌呤 HPLC≥98% 20mg
BMGY培养基100/500毫升 野鸢尾黄素 HPLC≥98% 20mg
BMMY培养基100/500毫升 刺甘草查尔酮 HPLC≥98% 20mg
BorreliaburgdorferiRFLP基因分析试剂盒20 刺芒柄花苷 HPLC≥98% 20mg
Bosc23包装细胞克隆选择培养基500毫升 刺囊酸 HPLC≥98% 20mg
Bouin固着液50毫升 刺桐碱 HPLC≥98% 20mg
BovineacetoneELISA试剂盒牛同检测(acetone)ELISA试剂盒规格:96T/48T 刺五加苷E HPLC≥98% 20mg
BPE蛋白标记试剂盒(不含BPE)3(1毫克/) 刺五加皂苷B HPLC≥98% 20mg
雷斯青霉图片大鼠戊糖素(Peosidine)试剂盒 Rat advanced glycation end products,AGEs ELISA Kit 甲基泼尼松 Meprednisone 质量规格:>98%,BR
英文名称RatFBELISAKit大鼠纤维蛋白原(FB)规格:96T/48T 甲基泼尼松(标准品) Meprednisone 质量规格:>98%,标准品
核固红复染试剂盒50 阿普斯特;CC10004 Apremilast;CC-10004 质量规格:>98%,PDE4和TNF-α抑制剂
ELISAKitFibrin人血纤蛋白规格:48T/96T L-(-)-葡萄糖(标准品) L-(-)-Glucose 质量规格:>98%,标准品
小鼠肌肝(Cr)ELISA试剂盒 组装/原装 7-酮基去氢表雄酮 7-Keto-dehydroepiandrosterone 质量规格:>98%
Rat lymphocyte function associated aigen 3 (LFA-3/CD58) ELISA Kit 大鼠细胞功能相关抗原3(LFA-3/CD58)ELISA试剂盒 硝酸铷 Rubidium nitrate 质量规格:>99%
Humaetinolbindingprotein,RBPELISAKit 人视黄醇结合蛋白(RBP)ELISA试剂盒 96T/48T 进口分装 CHIR-99021 (CT99021.HCl) CHIR-99021 (CT99021) HCl 质量规格:>99%,GSK-3α/β抑制剂
Humanai-lymphocytotoxicaibody,ALA/LCAELISA试剂盒人抗细胞毒抗体(ALA/LCA)ELISA试剂盒规格:96T/48T 骆驼蓬碱;骆驼蓬灵;哈梅灵(标准品) Harmaline;Dihydroharmine 质量规格:HPLC≥98%,标准品
植物尿苷二0酸葡萄糖焦0酸化酶(UDPglucosepyrophosphorylase)活性比色法定量检测试剂盒20 阿卡地新(AICAR) Acadesine 质量规格:>98%,BR
Humanurokinase-typeplasminogenactivator,uPA/PLAUELISAKit人激肽释放酶8(KLK8)ELISA试剂盒规格:96T/48T 蒲公英萜醇;蒲公英赛醇(标准品) Taraxerol 质量规格:HPLC≥98%,标准品
概念:
一,菌种的概念 原意是指孢子(相当于植物的种子) ,但在实际生产中,常将经过人工培养的纯菌丝体连同培养基质一同叫做菌种。
二,菌种的类型 在生产中根据菌种的来源,繁殖代数及生产目的,把菌种分为母种,原种和栽培种.分别叫一级种,二级种,三级种。
母种:将纯菌丝体或孢子在试管培养基中繁殖而成.可以繁殖原种,也适宜菌种保藏.
原种:母种菌丝在固体培养基上繁殖而成.这一过程增强菌丝对培养环境的适应性,又起到扩繁的作用.原种可以直接出菇。
风险提示:丁香通仅作为第三方平台,为商家信息发布提供平台空间。用户咨询产品时请注意保护个人信息及财产安全,合理判断,谨慎选购商品,商家和用户对交易行为负责。对于医疗器械类产品,请先查证核实企业经营资质和医疗器械产品注册证情况。
 技术资料
技术资料暂无技术资料 索取技术资料
雷斯青霉图片
询价